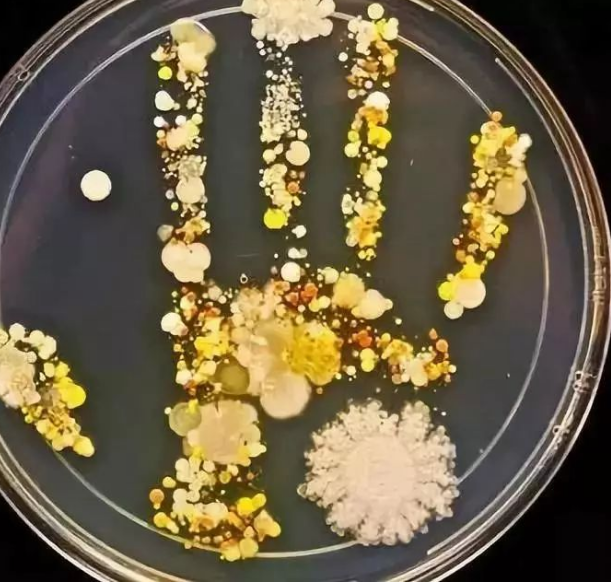
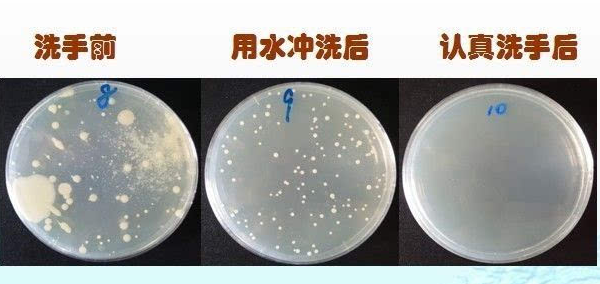

手到底有多臟,你知道嗎?
看著自己干干凈凈的雙手,你能想象到現(xiàn)在有多少細(xì)菌附著在上面嗎?
說出來數(shù)據(jù),估計很多人都不相信,科學(xué)家做過這樣一個調(diào)查,一只沒有洗過的手,至少含有4萬~40萬個細(xì)菌。指甲縫里更是細(xì)菌藏身的好地方,一個指甲縫里可以藏細(xì)菌達38億之多??谡f無憑,大家可以做個簡單的小實驗來驗證一下。
實驗驗證
第一步,準(zhǔn)備好營養(yǎng)瓊脂平板

第二步,將手指輕輕按壓于瓊脂表面
第三步,倒置于35°C的溫度下,培養(yǎng)48小時。觀察結(jié)果。
細(xì)菌來源
大家可以看到,手上的細(xì)菌五花八門,并不是單一的某一種細(xì)菌。那么為什么手上細(xì)菌那么多呢?
其實答案不難找出。我們的對外活動幾乎都是靠雙手來完成的,吃飯、按電梯、扔垃圾、拿手機、打掃衛(wèi)生......而細(xì)菌無處不在,我們生活的世界中遍布了各種細(xì)菌,雖然我們?nèi)庋劭床坏?,但是?dāng)我們用雙手來觸碰物品,比如電梯按鈕、公交扶手等的時候,雙手就已經(jīng)不知不覺染上了不計其數(shù)的病菌。
細(xì)菌危害
手上的病菌可能會帶來什么呢?
俗話說“菌從手來,病從口入”,傳染病患者和一些病毒攜帶者,常常把致病微生物傳播到各種用品器具上,當(dāng)健康人的手接觸后,致病微生物便來到你的手上。
當(dāng)我們的手沒有及時清潔消毒,就可能因為揉眼睛、摳鼻子、吃飯等動作,導(dǎo)致病菌進入人體內(nèi),從而導(dǎo)致一系列疾病的發(fā)生。比如,甲型肝炎、腹瀉、嘔吐、流感肺炎等,甚至一些更嚴(yán)重的傳染病。
如何預(yù)防
很簡單,勤洗手就行了!新冠疫情期間,勤洗手也是疫情防控、切斷病毒傳播的一個很重要的措施,由此可見勤洗手的重要性了。
洗手可除掉粘附在手上的細(xì)菌和蟲卵,通過正確洗手,保持手部衛(wèi)生,就能有效清除在洗手液或肥皂、流動的水來洗手時,肥皂盡可能要專人專用,公共場合盡量使用洗手液。流動水洗手要保證20秒以上。
手上大部分細(xì)菌,減少細(xì)菌傳播。
1、流動水充足的情況下,用洗手液或肥皂、流動的水來洗手,肥皂盡可能要專人專用,公共場合盡量使用洗手液。流動水洗手要保證20秒以上。
2、外出無法流水洗手時,同樣不能忽視手衛(wèi)生。卡麗凈季銨鹽消毒濕巾或免洗手消毒液也可以暫時替代流水洗手,能有效去除手部有害病菌。
洗手前后對比
看完這篇文章,你知道洗手的重要性了嗎?
以上為內(nèi)容導(dǎo)讀,完整內(nèi)容請點擊下方圖標(biāo)下載
